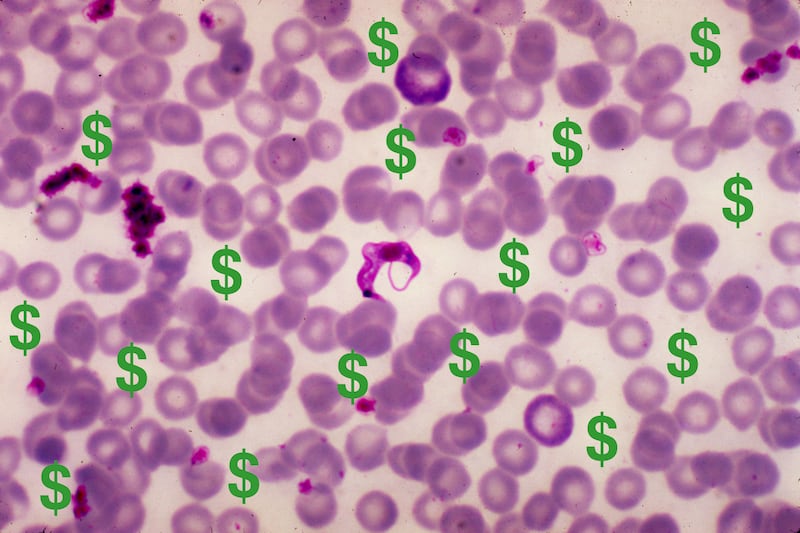

Of the many strange and even perverse ambitions in medicine, this is perhaps the most unsettling: every disease (or every expert behind every disease) wants to affect the most people.
To attend a medical meeting is like going to grade school on Grandparent's Day; but instead of learning about the incredible exploits of little Johnny, we hear that last year alone, lung cancer killed more people (160,000) than breast cancer (40,000), AIDS (8,500), motor vehicle accidents (34,000), and drug overdoses (38,000) combined. And—perversity of perversities—this comes from the experts themselves who are excited by the news.
Market share, it appears, is all.
And so it is no surprise to read the recent dispatch from the Centers for Disease Control regarding five parasitic diseases that have banded together as “five neglected parasitic infections (NPIs)” in hopes of scratching out a market niche. This race to the bottom features these five distinct misery machines: Chagas disease, which is endemic in many South American countries; cysticercosis (ditto and for Central America as well); toxocariasis (not too common in clinical care); toxoplasmosis (affects about 20% of the U.S. population); and trichomoniasis (affects almost 4 million people per year andis spread sexually).
Yet other than sharing some vague phylogenetic cousin-ry and perhaps some similarities in the way soil and excrement figure into the life cycle, these five diseases have zero similarities. (Oh, ok, they cause human disease and can be difficult to spell and they are infections, but nothing further unifies them.) They also raise the confusing question about the role of the U.S. and its deep-but-finite pockets in the control of diseases that affect those outside the U.S. much more than those who live here.
But the diseases threaten to be adrift in a sea of health-related information, just like the experts behind them and the CDC itself. The CDC’s job is to make citizens nervous enough that the citizens will make their congressmen nervous enough to keep the funding spigot open.
Those who think that such concern is simple academic paranoia in the absence of a clear and imminent danger should think again: one need only recall the mess that “abstinence” made of sexually transmitted infection control, or the bigger mess that gun control experts at the CDC face each year, or the really really large mess made by the CDC when it moved allotted funds from chronic fatigue to other infections. Without question, it is increasingly difficult for public health experts to know where its next dollar will come from.
As someone who has treated people with these diseases and one who certainly would love to see a wave of dollars suddenly lift the problems in diagnosis and treatment for each disease into the modern world, I must say that it is painful, actually, to read these PR memos.
But this misalignment of human suffering against the reality of paying to care for the unlucky souls with the disease is not the fault of the CDC. It’s a food fight out there: there’s just not enough money to go around. The battle of the diseases and their funding streams ramifies throughout medicine. Indeed, scientific articles have been written that attempt to square disease impact against financial investment.
But this is a loser’s argument, pitting one person’s tragedy against the next. Because when a single dollar is pulled between two diseases, everyone gets sick.




